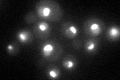
YIL091C
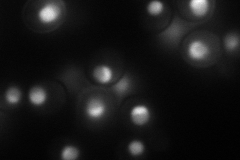
YIL091C
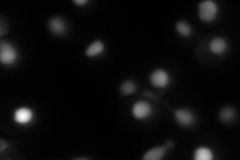
YIL091C

View description
Nucleolar protein of unknown function; proposed to function as an RNA helicase based on structure prediction and remote homology searches; essential for viability
Localization:
Intensity:
Fold change:
Significance:
-
C’ GFP library in SD
nucleolus48.63 -
N' NOP1pr-GFP in SD
nucleus,nucleolus91.784 -
N' TEF2pr-mCherry in SD
ER,vacuole115.268 -
N' NATIVEpr-GFP in SD

nucleolus53.8632 -
N' TEF2pr-VC and Cyto-VN in SD

#N/A0 -
C’ GFP library in SD+DTT

nucleolus41.670.85No -
C’ GFP library in SD+H2O2

nucleolus58.731.2No -
C’ GFP library in Starvation Media

nucleolus25.930.53Yes -
C’ GFP library on the background of Pup2-DaMP

nucleolus -
C’ GFP library on the background of CCT mutant

nucleolus57.05191.17311No
